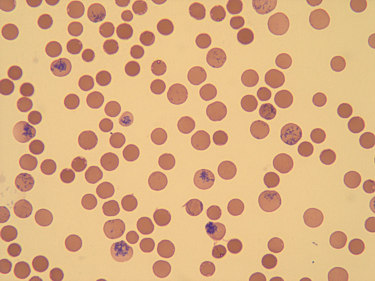

|
Anemias
Hemolíticas > Diagnóstico laboratorial 5 > Outros Exames |
|
Paciente:
RN de S. T. V.
Reticulócitos (Fig. 5.3):
30,2 % (881.840/mm3)
Dosagem de Bilirrubina (mg/dl)
Bilirrubina Total: 17,95
Bilirrubina Direta: 0,77
Bilirrubina Indireta: 17,18
|
|
    |
|
Figura 5.3: Reticulócitos.
|
|
|
|